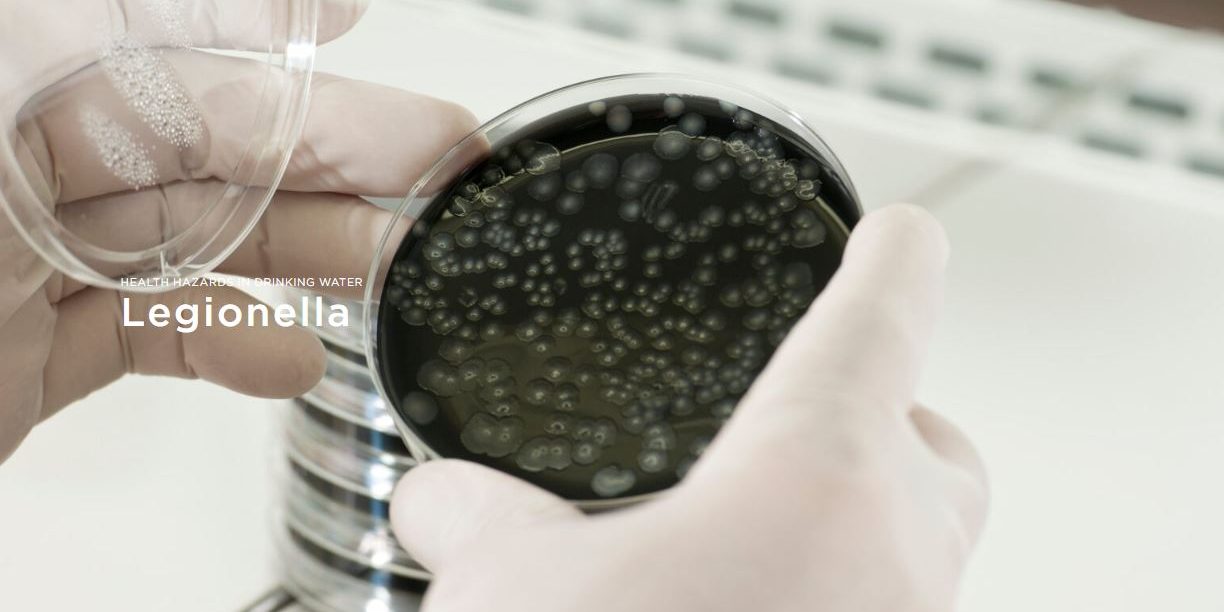
1 (1)

- su prirodni stanovnici naših tla i izvora pitke vode
- ne uklanjaju ih vodovodi
- ulaze u domaći vodovodni sistem u veoma malim koncentracijama i
- pronađu idealne uslove za razmnožavanje u vodovodnim cevima zgrada.
Koliko je opasna legionela?
Institut Robert Koh izbrojao je približno 1.281 prijavljeni slučaj* legionarske bolesti u Nemačkoj 2020. Broj neprijavljenih slučajeva je verovatno mnogo veći. CAPNETZ procenjuje godišnji broj slučajeva legionarske bolesti od oko 15.000 do 30.000 slučajeva* u Nemačkoj.
*Izvor: https://www.rki.de/DE/Content/Infekt/Jahrbuch/Jahrbuch_2020.pdf?__%20blob=publicationFile
CAPNETZ: Nemačka mreža kompetencija za pneumoniju stečenu u zajednici
Vodovodne cevi – idealno životno okruženje za bakterije legionele
Višeslojni biofilm se formira na unutrašnjem zidu cevi za kućnu vodu u roku od samo jedne godine.
Biofilm na zidu cevi obezbeđuje hranu za legionelu i druge klice.
Svaki metar cevi od 3/4 inča obezbeđuje stanište za oko 6 milijardi bakterija!
Biofilm na zidu cevi štiti legionelu od dezinfekcionog dejstva tople vode i hlora!
Koliko je klica u vodi za piće
Naučnici su dokazali da voda za piće sadrži 10.000 do 200.000 aktivnih ćelija po mililitru!
Klice se obično otkrivaju putem razmaza na hranljivoj podlozi. Rezultat je samo ograničenog značaja.
- Bris pokazuje samo klice koje stvaraju kolonije.
- Razmaz pokazuje samo klice koje zahtevaju kiseonik i srednju temperaturu.
- Određivanje vrste klica nije moguće.
- Samo oko 0,1-1% klica uopšte formira kolonije.
Takozvana protočna citometrija je mnogo preciznija metoda detekcije, ali veoma složena i skupa.
Naše rešenje: Seccua MK7